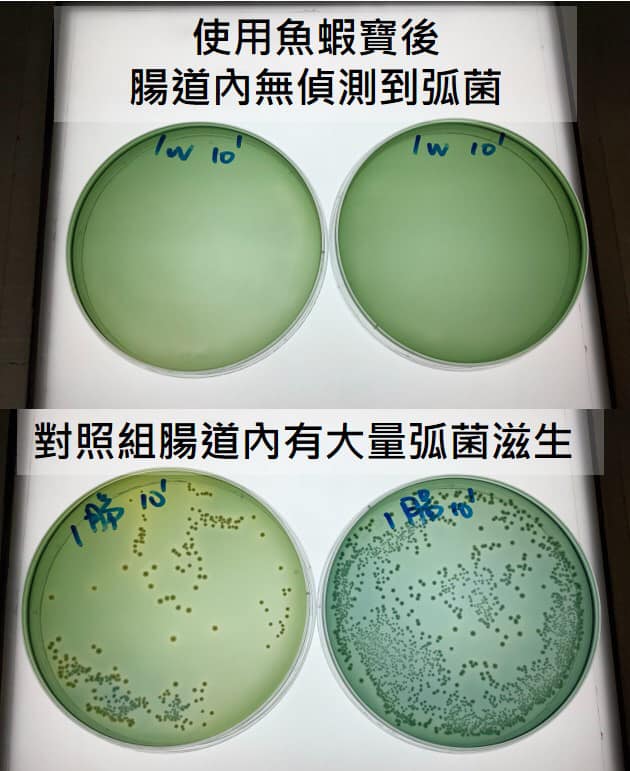

最新
消息
消息
各位朋友大家午安,最近天氣日夜溫差大,真的是很容易感冒生病呢,小編在這邊提醒大家注意身體健康、勤洗手還有外出記得戴口罩!
只是,你以為在換季時容易生病的只有人類嗎?NONONO(搖手指),其實白蝦也會喔~ 最近季節交替,忽冷忽熱又下雨的天氣,便使得各地蝦塭災情頻傳,輕則退料,重則引起大量死亡。
此時,來用用看神農魚蝦寶吧!
魚蝦寶針對包括弧菌在內的多種病原菌有顯著抑制作用。本次客戶使用魚蝦寶約一個月,與未投菌的對照組相比,使用魚蝦寶的養殖池蝦體弧菌量少了99.9%,且成長快速,比同批放養的對照組蝦苗體重高出近一倍!此外,對照組有諸多蝦體出現紅腸、軟殼等弧菌感染病徵,客戶看見顯著效果後立馬回購,預計在所有池子中皆使用魚蝦寶!
您的池子和愛蝦最近怪怪的?讓神農魚蝦寶來與您一同防疫!
愛用神農魚蝦寶,早早收成沒煩惱!
※防疫小叮嚀:過度投料會造成池水快速惡化,不但不會長得快反而容易造成弧菌滋生喔!
【神農Line@】
https://line.me/R/ti/p/%40uyg1686u
#神農魚蝦寶
#弧菌抑制
#白蝦
#弧菌感染
#紅腸
#軟殼
#季節變換
#芽孢桿菌
#水產益生菌
#EHP
#EMS